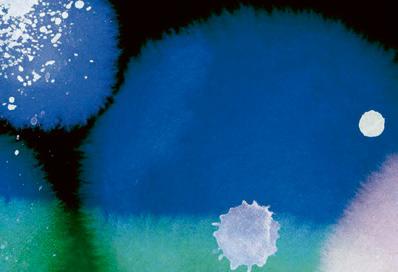
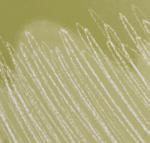

Sternenreisen:



![]()















Sternenreisen:



Passend zu den bunten Herbstblättern haben wir in den kommenden Monaten ein besonders buntes Programm für Sie zusammengestellt. Wenn die Tage wieder kürzer werden und die Temperaturen kühler, zieht es uns alle nach drinnen. Daher hoffen wir, Sie in unserem gemütlichen Sternensaal begrüßen zu dürfen – vielleicht sogar mehrmals. Anlass dazu gibt es genug! So stehen im Herbst ganz besonders viele Highlights der Sparte „Musik & Kultur“ auf dem Spielplan. Erleben Sie zum Beispiel unsere neue Show COSMIC OPERA, entstanden in Koproduktion mit der Stiftung Planetarium Berlin. Des Weiteren können Sie jüdische Kammermusik in JÜDISCHE STERNSTUNDEN genießen, mit 360° KOSMOS SUITE in eine LiveJazz-Performance mit virtuellem Chors eintauchen oder sich bei KLAVIERE UNTERM STERNENHIMMEL von zwei Klavieren auf der Bühne des Sternensaals verzaubern lassen. Doch damit nicht genug: Lernen Sie zwei neue Bücher im Rahmen des Harbour Front Literaturfestivals kennen und gruseln Sie sich rund um Halloween bei FRANKENSTEIN. Sie sehen, unser Programm ist reich an kulturellen Höhepunkten. Doch was wäre das Planetarium ohne astronomische Highlights? Neben unseren beliebten Klassikern möchten wir Ihnen

ganz besonders einen Vortrag zu den PIONIERINNEN IN DER PHYSIK ans Herz legen. In unserer Reihe VOSS‘ KOSMOS erfahren Sie außerdem Spannendes über DIE KOSMISCHE GESCHICHTE VON WASSER und wir stellen gemeinsam die Frage: WIE UNTERHÄLT MAN SICH MIT AUSSERIRDISCHEN?
Werfen Sie einen Blick auf unseren Spielplan und die Vielzahl an Veranstaltungen in den Herbstmonaten – es ist für jeden Geschmack etwas dabei.
Übrigens: Wiederkommen lohnt sich! Holen Sie sich direkt im Planetarium Hamburg unseren PLANETENPASS, mit dem Sie bei jedem Besuch einen Stempel sammeln. Die sechste Vorstellung ist kostenlos. Nähere Informationen dazu erhalten Sie auf der nächsten Doppelseite.

Wir wünschen Ihnen einen schönen Herbst und freuen uns auf Ihren Besuch!
















5 VERANSTALTUNGEN BEZAHLEN, DIE 6. KOSTENLOS ERLEBEN!
Mit dem neuen PLANETENPASS belohnen wir Ihre Treue. Sie besuchen fünf Veranstaltungen im Planetarium Hamburg und wir schenken Ihnen den Besuch der sechsten!
Um an der Aktion teilzunehmen, benötigen Sie nur den PLANETENPASS in Form einer „Stempelkarte“, die Sie kostenlos im Planetarium Hamburg erhalten. Gesammelt werden können die Stempel bei allen unseren Veranstaltungen. Sie erhalten ihn beim Entwerten Ihres Tickets direkt auf Ihren Planetenpass. Nach dem fünften Mal können Sie Ihren „Freiflug“ einlösen: Sie erhalten eine Freikarte für eine Veranstaltung mit einem Ticketpreis von bis zu 15 Euro. Damit können Sie alle unsere Veranstaltungen in den
Sparten „Sternenreisen“, „Planet Erde“ und „Kinderveranstaltungen“ besuchen sowie die regulären Shows im Bereich „Musik & Kultur“.
Nähere Teilnahmebedingungen finden Sie online unter: www.planetarium-hamburg.de/planetenpass
Die Aktion läuft bis Ende März 2026 – bis dahin können Stempel gesammelt und Freikarten eingelöst werden.
Greifen Sie mit uns nach den Sternen und lassen Sie sich belohnen!
Kennen Sie eigentlich schon den Förderverein Planetarium Hamburg e.V.?
Der Förderverein Planetarium Hamburg e.V. dient der ideellen, finanziellen und materiellen Unterstützung des Planetarium Hamburg. Seine Mitglieder unterstützen auf vielfältige Weise die Entwicklung des Sternentheaters. Ein besonderes Anliegen ist es, Jugendliche sowie Schülerinnen und Schüler an Themen in den Bereichen Umwelt und Kosmos heranzuführen.
Fördern und Mitmachen
Werden Sie Mitglied im Förderverein – schon ab 30 € im Jahr. Ein weiterer Schwerpunkt ist das Gewinnen von Sponsoren und Mäzenen. Mitglieder des Vereins und Sponsoren haben die Möglichkeit, an Premieren, Ausstellungen und Veranstaltungen im Planetarium teilzunehmen.
Sternpatenschaft
Übernehmen Sie die Patenschaft für Ihren Stern am Himmel des Planetarium Hamburg. Sie suchen sich dazu das Sternbild aus, in dem sich der Stern befinden soll. Näheres unter sternpaten.fvplanetarium.de




Unter dem Motto „Beobachten, staunen, erleben“ laden bundesweit astronomische Einrichtungen wie Planetarien und Sternwarten am 13. September 2025 zur „Langen Nacht der Astronomie“, um mit ihrem abwechslungsreichen Programm die Begeisterung für die Astronomie zu teilen.
Auch das Planetarium Hamburg beteiligt sich in diesem Jahr wieder am deutschlandweiten Aktionstag und lässt Sie das Universum auf unterschiedliche Arten entdecken.
Wir zeigen den Abend über verschiedene astronomische Live-Kurzvorstellungen, bei denen unsere Moderatoren Sie in spannende und
aktuelle Themen der Astronomie mitnehmen. Außerdem laden wir Sie mit Teleskopen zu Live-Beobachtungen des Sternenhimmels ein und runden unser Programm mit weiteren Mitmachaktionen ab. Und das alles bis nach Mitternacht!
Mit einem speziellen Ticket kommen Sie in den Genuss aller Programmpunkte und können mit uns und vielen weiteren Einrichtungen bundesweit die „Lange Nacht der Astronomie“ erleben!
Das genaue Programm wird im Sommer 2025 auf unserer Website veröffentlicht.
Sa., 13. September, ab 19:00 Uhr





Was ist gerade am Hamburger Nachthimmel zu sehen? Wir nehmen Sie mit auf einen nächtlichen „Spaziergang“, bei dem Sie in Zeitraffung den aktuellen Lauf von Sonne, Mond und Planeten erleben. Außerdem zeigen wir Ihnen die wichtigsten Sternbilder und erklären Ihnen, wie Sie diese ganz leicht selbst am Himmel finden können.
Empfohlen ab 10 Jahren | Dauer: ca. 50 Minuten
Im Jahr 1969 verfolgten Millionen Menschen vor Fernsehern und Radios die Apollo-11-Mission, die die ersten Astronauten auf den Mond brachte. Erleben Sie die faszinierende Geschichte des Wettlaufs ins All und der Mond-Missionen in einem spannenden 3D-Erlebnis. Vom aktuellen Lauf des Mondes am irdischen Nachthimmel zu den ersten Schritten auf dem Mond. Empfohlen ab 10 Jahren | Dauer: ca. 55 Minuten
Partially available in


Unser Universum entstand vor etwa 14 Milliarden Jahren – es befindet sich im ständigen Wandel. Was geschieht in ferner Zukunft? Was bleibt, wenn sämtliche Sterne verlöschen? Was passiert in Jahrmilliarden, wenn die Sonne das Ende ihrer Existenz erreicht und sich die gesamte Milchstraße spektakulär wandeln wird? Kommen Sie mit auf eine astronomische Zeitreise in die fernste Zukunft!
Empfohlen ab 12 Jahren | Dauer: ca. 55 Minuten
Fully available in

Sternwolken und Sternbilder zeigen sich entlang der Ebene unserer Milchstraße. Lernen Sie die Sterne in ihrer Vielfalt kennen – jeder einzelne mit seiner eigenen, unverwechselbaren Geschichte, von seiner Geburt aus Wolken von Staub bis zu seinem Ende. Wie lange existieren sie, auf welche Art gehen sie unter und welche Zukunft erwartet unsere Sonne?
Empfohlen ab 12 Jahren | Dauer: ca. 50 Minuten
Fully available in






Unbemannte Raumsonden haben alle Planeten unseres Sonnensystems erkundet und Spannendes entdeckt. Aber noch hat kein Mensch eine dieser Welten besucht. Nur im Planetarium erleben wir diese Orte schon heute wie die Raumfahrenden der Zukunft. Reisen Sie durch unser Sonnensystem und entdecken Sie die Planeten hautnah! Empfohlen ab 10 Jahren | Dauer: ca. 55 Minuten
Partially available in


Was sind Schwarze Löcher? Warum gibt es sie? Welche Geheimnisse verbergen sie? Diese Fragen führen uns an die Grenzen des menschlichen Wissens und darüber hinaus.
Vor einigen Jahrzehnten war die Existenz Schwarzer Löcher Gegenstand wilder Spekulationen. Heute wissen wir, dass sie real und außergewöhnlich sind. Diese unsichtbaren Riesen verzerren die Raumzeit, verschlingen Sterne und senden Wellen durch das Gefüge des Universums – Gravitationswellen, die wir hier auf der Erde feststellen können.
Die Rätsel der Schwarzen Löcher zu entschlüsseln, ist eine der größten Herausforderungen der Menschheit und erfordert unsere besten Köpfe und modernste Technologie.
Bereiten Sie sich auf ein Abenteuer vor, das unser Verständnis von Raum, Zeit und Schwerkraft auf die Probe stellt. Sind Sie bereit, ins Unbekannte einzutauchen?
Empfohlen ab 12 Jahren | Dauer: ca. 50 Minuten
Fully available in




Lernen Sie Planeten, Sterne, Galaxien und die unvorstellbaren räumlichen Tiefen des Weltalls auf spektakuläre Art und Weise kennen. Wir fliegen mit Ihnen von der Erde bis hin zum Rand des beobachtbaren Universums – mit Echtzeit-Simulationen des Alls und in faszinierender 8K-Bildqualität. Nie waren uns die Sterne so nah und der Kosmos so hautnah erlebbar wie hier!
Empfohlen ab 12 Jahren | Dauer: ca. 60 Minuten
In 2D und 3D auf dem Spielplan




Entdecken Sie einige der spannendsten Sternbilder der vier Jahreszeiten und erfahren Sie, welche mythologischen Ursprünge sie haben: Legenden über Gottheiten, Ungeheuer, Fabelwesen – von tragischen Liebesgeschichten bis zu spannenden Abenteuern. Gleichzeitig erklären wir Ihnen, wie Sie die markanten Konstellationen selbst am sternklaren Himmel ausmachen können. Empfohlen ab 10 Jahren | Dauer: ca. 50 Minuten
Partially available in

Tief unter der Erdkruste gibt es eine enorme Artenvielfalt von Mikroorganismen, die unter extremen Bedingungen gedeihen. Dieses „verborgene Leben“ fordert uns heraus, nicht nur den Ursprung und die Entwicklung des Lebens auf der Erde, sondern auch seine mögliche Existenz anderswo im Universum zu überdenken. Leben im Kosmos könnte viel verbreiteter sein, als wir dachten. Was werden wir entdecken?
Empfohlen ab 12 Jahren | Dauer: ca. 50 Minuten
Partially available in

Die Voyager-Missionen nahmen im Spätsommer 1977 ihren Anfang. Im August startete zunächst Voyager 2 ins All, Voyager 1 folgte kurz darauf. Als „reisende Reporter“ besuchten sie die Planeten Jupiter, Saturn, Uranus und Neptun. Dabei übermittelten sie uns spektakuläre neue Einsichten in diese fernen Riesenwelten und ihre bizarren Monde.
Empfohlen ab 10 Jahren | Dauer: ca. 45 Minuten
Partially available in


Woraus bestehen die Sterne und woraus bestehen wir? Willkommen im magischen Wunderzirkus des Universums! Zirkusdirektor Bastian Pastewka schickt uns mit seiner geheimnisvollen Zeitmaschine 13,8 Milliarden Jahre durch Raum und Zeit. Vom Urknall zu explodierenden Sternen bis hin zur Entstehung des Lebens – auf den Spuren der chemischen Bestandteile des Kosmos.
Empfohlen ab 10 Jahren | Dauer: ca. 45 Minuten
Partially available in







VORTRAG: PIONIERINNEN IN DER PHYSIK
Lise Meitner (1878-1968) hat als Erste erkannt, wie Kernspaltung möglich ist. Vera Rubin (1928-2016) hat die Dunkle Materie entdeckt. Beiden ist es gelungen, zu einer Zeit, in der die akademische Welt sehr von Männern dominiert war, entscheidende wissenschaftliche Beiträge zu leisten. Prof. Dr. Beate Heinemann präsentiert die Leben und Leistungen der beiden Pionierinnen. Do, 30. Oktober, 19:30 Uhr | Dauer: ca. 90 Minuten
Vortrag von Prof. Dr. Heinemann Vorsitzende des DESY-Direktoriums
In dieser Reihe präsentiert Planetariumsdirektor Dr. Björn Voss regelmäßig aktuelle Themen aus der Welt der Astronomie und aus angrenzenden Disziplinen in anschaulicher Weise. Ob es um spannende Entdeckungen in den Weiten des Weltalls, um die Entstehung von Sternen oder um die neuesten Erkenntnisse aus der Weltraumforschung geht – erleben Sie faszinierende Einblicke in den vielfältigen Kosmos.
Dauer: jeweils ca. 90 Minuten
WASSER – EINE KOSMISCHE GESCHICHTE
Do., 16. Oktober, 19:30 Uhr
Diese Substanz prägt unseren Planeten und wir alle hängen von ihr ab: Wasser, H₂O. Die Suche nach dem Ursprung des „Stoffs des Lebens“ führt zurück bis zum Urknall und bis in das heiße Innere der Sterne. Der weitere Weg unseres Wassers führt durch kosmische Wolken und vorbei an Kometen bis hin zur Entstehung der Ozeane unseres Planeten.
WIE UNTERHÄLT MAN SICH MIT AUSSERIRDISCHEN?
Do., 6. November, 19:30 Uhr
Die Unterhaltung mit Außerirdischen erscheint in der Realität noch nicht von praktischer Relevanz. Aber schon heute wird der Himmel nach Signalen fremder Intelligenzen abgesucht. Es werden sogar Botschaften „auf gut Glück“ zu den Sternen gesandt. Doch wie formuliert man solche, damit sie auch verstanden werden können? Und wie würde man vorgehen, wenn tatsächlich ein Signal aus dem All käme?

Im Planetarium können wir den wunderschönen Sternenhimmel klar bewundern, die „Nacht“ zeigt sich tiefschwarz – wie in der freien Natur fernab von Städten und störenden Lichtquellen. Der von Natur aus dunkle Sternenhimmel war auch für unsere Vorfahren jahrtausendelang eine Inspirationsquelle. Ist es nicht seltsam, dass wir heute in entlegene Gebiete reisen müssen, um ihn in seiner vollen Pracht betrachten zu können?
Durch künstliche Lichtquellen ist der Nachthimmel vor allem in Städten sehr aufgehellt – die Sterne sind kaum zu sehen, die Milchstraße meist gar nicht. Diese Lichtverschmutzung trübt aber nicht nur den Blick in die Sterne,
sondern kann auch Pflanzen, Tiere und Menschen irritieren und negativ beeinträchtigen.
Selbst aus dem All sind die vielen künstlichen Lichtquellen, die nach oben abstrahlen und sich in den atmosphärischen Schichten reflektieren und zerstreuen, zu sehen.
Warum und wie wir Menschen unsere Umwelt durch Lichtverschmutzung stören, welche Auswirkungen sie auf uns und auf die Natur als Ganzes hat und was jeder von uns dagegen unternehmen kann, erfahren Sie in „Die Dunkle Seite des Lichts“.

Fully available in Empfohlen ab 10 Jahren | Dauer: ca. 50 Minuten | Eintritt: 12 Euro, ermäßigt 7,50 Euro



Das Polarlicht ist die wohl wunderbarste Naturerscheinung, die man erleben kann – als „Aurora Borealis“ im hohen Norden und als „Aurora Australis“ im tiefen Süden. Dem koreanischen Astrofotografen Kwon O Chul gelang es, diese Leuchterscheinung in ihrer facettenreichen Schönheit in Echtzeit und 4K-Auflösung kuppelfüllend einzufangen – ein grandioser Tanz der Formen und Farben an der großen Sternenkuppel! Originalaufnahmen von Bord der Internationalen Raumstation ISS und naturgetreue Computer-Visualisierungen bringen uns Legenden ebenso wie die wissenschaftliche Untersuchung der Polarlichter näher. Dabei blicken wir auch mit unserem Zeiss-Himmelssimulator in den Sternenhimmel über Nordnorwegen und finden den besten Ort und die beste Zeit, um das kosmische Farbenspiel mit eigenen Augen sehen zu können.
Empfohlen ab 10 Jahren | Dauer: ca. 60 Minuten
Partially available in

Was haben alle lebenden Dinge gemeinsam? Wie winzig sind Moleküle? Was passiert in unseren Zellen, nachdem wir gegessen haben? „Die Chemie des Lebens – Das Unsichtbare in uns“ macht die biomolekulare Welt durch modernste Visualisierungen konkreter und zugänglicher. Die Produktion konzentriert sich darauf, die mit dem Leben verbundenen Prozesse – Atmen, Essen und Denken – mit biochemischen Prozessen in den Zellen des Körpers zu verbinden. Um diese Chemie des Lebens zu erkunden, reisen wir tief in die Zellen von Pflanzen und Menschen.
Mit Hilfe von dynamischen Animationen, die auf Forschungsdaten basieren, und dem immersiven Kuppelformat erleben wir die molekulare Welt auf eine ganz neue Weise und erlangen ein tieferes Verständnis für die unsichtbare Welt, die in uns allen existiert.
Empfohlen ab 12 Jahren | Dauer: ca. 55 Minuten
Partially available in



Achill und Aaron Moser berichten mit fantastischen Fotound Filmaufnahmen von ihrer monatelangen Kanadareise. Zu Fuß, im Kajak und per Geländewagen führt die Expedition von den rauen Küsten des Atlantiks zu den grandiosen Gebirgsmassiven der Rocky Mountains bis hin zum Pazifik. Das Vater-Sohn-Gespann bewundert großartige Naturlandschaften, trifft Trapper, First Nations und Auswanderer und besucht die pulsierenden Städte Québec, Montréal, Calgary und Vancouver. Auf sich allein gestellt erleben die beiden die Gefahren einer ungezähmten Natur, die sie an ihre Grenzen bringt: reißende Stromschnellen, Stürme, Waldbrände, Gewitterfronten – dazu Begegnungen mit Wölfen, Schwarzbären, Moschusochsen, Karibus und Weißkopfseeadlern. Kommen Sie mit auf eine emotionale Entdeckungsreise. Das Programm wird von Chris Hanson begleitet, der mit seinen Live-Gitarrenklängen zum Träumen anregt.
So., 28. Sept., 19:00 Uhr & So., 26. Okt., 19:00 Uhr
Dauer: ca. 120 Minuten (inkl. Pause) | Eintritt: 24 Euro
Seit Jahren unternehmen Achill Moser und Aaron Moser Expeditionen durch die ganze Welt. Das Zu-Fuß-Reisen in Wüsten, Regenwäldern und Bergwildnis ist ihre große Leidenschaft. Aber auch das eigene Land wollten sie genauer kennenlernen. Also machten sie sich auf den Weg – von der Nordsee zur Zugspitze. Eine 1.600 Kilometer lange Wanderung durch sechs Bundesländer; über schlickiges Watt, einsame Pfade und historisches Pflaster; durch dunkle Wälder, tiefe Schluchten und grandiose Landschaften.
Im Sternensaal mit Projektionen an der Sternenkuppel berichten Vater und Sohn in ihrer Live-Show mit faszinierenden Foto- und Filmaufnahmen von ihrer 87-tägigen Wanderung, die einen neuen Blick auf Deutschland und ein Gefühl von Heimat vermittelt. Kommen Sie mit auf ein fantastisches Wanderabenteuer. Denn: Nur zu Fuß hält die Seele Schritt.
So., 2. November 19:00 Uhr | Empfohlen ab 10 Jahren
Dauer: ca. 110 Minuten (inkl. Pause) | Eintritt: 22 Euro

Die neue Show COSMIC OPERA stellt die bekanntesten und mitreißendsten Opern in den Mittelpunkt und lässt die Tradition einer Jahrhunderte alten Kunstform als moderne Planetariumsshow in neuem Licht erscheinen.
Lassen Sie sich von Melodien aus „Carmen“, „La traviata“, „Tannhäuser“, „Hoffmanns Erzählungen“ und vielen weiteren Meisterwerken verzaubern. Schwelgen Sie im „Lied an den Mond“ aus der Oper „Rusalka“, erleben Sie das weltberühmte „Nessun dorma“ aus „Turandot“ und genießen Sie eine der berühmtesten Arien der Opernwelt mit einer emotionsgeladenen Lasershow, wenn die Königin der Nacht aus Mozarts „Die Zauberflöte“ „Der Hölle Rache“ beschwört.
Während Arien, Instrumental- und Chornummern aus unserer 360-Grad-Anlage einen allumfassenden Sound erzeugen, der Sie ganz ins Geschehen eintauchen lässt, erscheinen an der Sternenkuppel stimmungsvolle Bildwelten aus dem Kosmos. Wir reisen vom Urknall durch Raum und Zeit bis an den Rand des Universums, erkunden unser Sonnensystem, den Asteroidengürtel, ferne Sterne und tauchen sogar ins Innerste unserer Sonne ein, wo Sie eine Licht- und Lasershow erwartet.
Genießen Sie die vielen Ohrwürmer der Opernwelt und tauchen Sie ein in COSMIC OPERA!
Premiere am 10. Oktober 2025
Eine Koproduktion mit der Stiftung Planetarium Berlin.
Dauer: ca. 75 Minuten | Eintritt: 12 Euro, ermäßigt 7,50 Euro





Diese „Playlist für Weltraumreisende” ist ein Ritt durch Sternen- und Fantasiewelten aus 60 Jahren Raumfahrt mit Musik aus der Apollo-Ära und Tracks, die von den Apollo-Missionen inspiriert sind. Musikalisch reicht die Palette von Coldplay über Chris Hadfield bis zu Udo Lindenberg. Eine Musikshow mit Sternenflügen, 3D-Visualisierungen und Laser-Effekten.
Dauer: ca. 75 Minuten | Eintritt: 15 Euro
„Look to the sky“: Begleitet von den schönsten Melodien aus dem Kosmos des Jazz, begeben wir uns auf einen Ausflug ins Weltall. Wir fliegen zu einem Ort „East of the Sun and West of the Moon“, erklimmen die „Stairway to the Stars“ und reisen mit „Fly me to the Moon“ zu unserem nächsten Nachbarn, um schließlich wieder sanft unter den „Blue Skies“ unseres Heimatplaneten zu landen.
Dauer: ca. 60 Minuten
Eintritt: 12 Euro, ermäßigt 7,50 Euro
Genießen Sie die Lesung eines der schönsten „Märchen für Erwachsene”, feinfühlig vorgetragen von Clemens von Ramin und von stimmungsvoller Musik begleitet.
Saint-Exupéry erscheint uns in der Gestalt des Fliegers, dem die Begegnung mit dem kleinen Prinzen das Herz öffnet. Ein zeitlos gültiges Plädoyer für Freundschaft und Menschlichkeit.
Empfohlen ab 12 Jahren | Dauer: ca. 90 Minuten
Eintritt: 22 Euro
Im abgelegenen Dorf Redwood Falls staunen die drei Detektive Justus Jonas, Peter Shaw und Bob Andrews nicht schlecht. Die hiesigen Menschen lehnen jegliche Art des Fortschritts ab. Es kommt ihnen so vor, als wäre die Zeit dort stehen geblieben. Ziemlich schnell ist es allerdings vorbei mit der Ruhe, denn das Dorf der Teufel zeigt sein wahres Gesicht.
Empfohlen ab 10 Jahren | Dauer: ca. 95 Minuten
Eintritt: 18 Euro, ermäßigt 13 Euro












In einem Umzugskarton stoßen die drei ??? auf eine alte Steinfigur und eine Karte mit geheimen Schriftzeichen, die vom Volk der Maya zu stammen scheinen. Welches Geheimnis bergen sie? Als Justus, Bob und Peter klar wird, dass zwielichtige Gestalten sehr an der Lösung des Rätsels interessiert sind, entspinnt sich ein gefährlicher Wettlauf gegen die Zeit … Ein Hörspiel unter dem Sternenhimmel.
Empfohlen ab 10 Jahren | Dauer: ca. 130 Minuten
Eintritt: 18 Euro, ermäßigt 13 Euro
Rechtzeitig zur Weihnachtszeit wird die Uraufführung einer neuen Folge der immersiven Hörspielserie bei uns im Planetarium Hamburg stattfinden und ab dann auch regelmäßig auf dem Spielplan stehen. Aber pssssst: Alles Weitere ist vorerst noch geheim. Ab September lohnt der Blick auf unsere Website.
Empfohlen ab 10 Jahren | Dauer: ca. 105 Minuten
Eintritt: 18 Euro, ermäßigt 13 Euro
VVK-START: 17.09.2025, 00:00 Uhr
In ELECTRIC LIGHTS geht es um die Energie und Kraft von Frauen in der elektronischen Musik: ihre Leidenschaft, ihre Erfahrungen und ihre einzigartigen künstlerischen Perspektiven. Die Fotografin und DJ Katja Ruge bespielt gemeinsam mit von ihr porträtierten Künstlerinnen die Kuppel des Planetarium Hamburg. Die Verbindung von Weltraumforschung, elektronischer Musik und Fotografie macht das Planetarium zur perfekten Spielstätte. Denn sie alle beruhen auf der intensiven Nutzung von Technologie.
In Ausgabe 5 erscheint sie mit JakoJako, die für ihre energiegeladenen Live-Sets zwischen Struktur und Spontaneität bekannt ist. Als vielgefragte Performerin bespielt sie als Resident regelmäßig das Berliner Berghain, ist auf Festivals wie dem Fusion zu erleben, füllt aber auch die Royal Albert Hall und das Barbican.
Di., 18. November & Mi., 19. November, jeweils 20:00 Uhr
Dauer: ca. 150 Minuten (inkl. Pause) | Eintritt: 24 Euro



FRANKENSTEIN
Das Theater ex libris präsentiert in diesem packenden LiveHörspiel mit fünf Schauspielenden, Live-Musik und Visuals die berühmte Geschichte von Victor Frankenstein. Die Schauererzählung aus dem Jahr 1818 ist gleichzeitig der erste Science Fiction-Roman, denn Autor Mary Shelley ersann darin, wohin der Wissenshunger und Forschergeist uns führen könnten.
Fr., 24. Oktober, 20:00 Uhr
Dauer: ca. 150 Minuten (inkl. Pause) | Eintritt: 22 Euro
Lesung und Podiumsdiskussion
Der Astrophysiker Heino Falcke begibt sich mit dem Wissenschaftsjournalisten Jörg Römer auf die Suche nach den Ursprüngen unseres Universums und fragt nach: Was ist das Leben? Wie konnte unsere Welt entstehen? Welche Rolle spielt Gott für unser Dasein? Und: Was ist der Mensch überhaupt? Falcke und Römer gelingt in ihrem neuesten Buch eine atemberaubende Reise vom Anfang bis zum Ende unserer Welt. Mi.,24. September, 19:30 Uhr | Dauer: 90 Minuten
Eintritt: 12 Euro, ermäßigt 7,50 Euro
Eine interstellare Reise zu Hamburgs jüdischen Komponistinnen
Das Jewish Chamber Orchestra Hamburg (JCOHH) lädt zu einer außergewöhnlichen musikalischen Reise ins Planetarium Hamburg ein. Im Mittelpunkt stehen herausragende jüdische Komponistinnen wie Felicitas Kukuck, Ruth Schönthal, Fanny Hensel und Alma Mahler, deren Werke einst im Schatten standen. Ihre Musik erklingt in einem einzigartigen Zusammenspiel mit der faszinierenden Welt der Astronomie. Begleitet von atemberaubenden Sternenprojektionen erzählt das JCOHH auch von den „unsichtbaren“ Pionierinnen der Astrophysik – darunter Vera Rubin, Tochter jüdischer Einwanderer, die die Dunkle Materie entdeckte. Ein Abend voller Musik, Wissenschaft, Inspiration und starker Frauen.
Do., 25. September, 19:30 Uhr | Dauer: 120 Minuten
Eintritt: 19 Euro


Das Duo EdenWolf lädt zu einem Konzert mit gleich zwei Flügeln unterm Sternenhimmel. Vier Hände auf 176 Tasten. Im ersten Teil des Konzerts erwartet Sie ein faszinierender Bogen von Wolfgang Amadeus Mozarts Ouvertüre aus »Die Zauberflöte« in einer Klavierfassung von Ferruccio Busoni bis hin zu Sergei Rachmaninows Suite für zwei Klaviere (op.17). Im zweiten Teil entfaltet sich ein monumentales Klanguniversum: „Die Planeten“, die epische Orchestersuite von Gustav Holst in einer spektakulären Fassung für zwei Klaviere.
Die 360-Grad-Visuals an der Planetariumskuppel übersetzen die Klänge in eindrucksvolle kosmische Bilderwelten.
Sa., 15. Nov., 20:00 Uhr & So., 16. Nov., 11:00 Uhr
Dauer: ca. 110 Minuten (inkl. Pause) | Eintritt: 29 Euro



Coole Beats und leichte Sounds, KONTOR SUNSET CHILL aus dem Hause des Hamburger Labels KONTOR RECORDS ist Deutschlands erfolgreichste Compilation-Serie dieses Genres und hat sich in den vergangenen knapp zwei Jahrzehnten zu einer eigenständigen Marke entwickelt.
Mit KONTOR SUNSET CHILL kann man sich in Urlaubsstimmung versetzen und den Alltag hinter sich lassen. Coole Beats und leichte Sounds liefern den Soundtrack zu einem relaxten Lebensgefühl. KONTOR ist Kult! Resident DJ MARKUS GARDEWEG und ein wechselnder Special Guest – im Oktober SONO – bringen den KONTOR SUNSET CHILL Spirit ins Planetarium Hamburg und sorgen für einen unvergesslichen Abend.
Mi., 29. Oktober, 20:15 Uhr
Dauer: ca. 120 Minuten (inkl. Pause) | Eintritt: 20 Euro


LUKAS DERUNGS –KOSMOS SUITE 360°
Lukas DeRungs Debut-Album KOSMOS SUITE, nominiert für den Deutschen Jazzpreis und ausgezeichnet mit dem Landesjazzpreis Baden-Württemberg 2024, wird zur Planetariumsshow – mit Live-Band, Live-Gesang, virtuellem Chor in 3D-Sound und ausdrucksstarken 360-Grad-Visuals.
Erleben Sie die emotionale Dichte eines vielstimmigen Vokalensembles in Kombination mit der physischen Energie einer improvisierenden Jazzformation. Basierend auf englischen Texten zeitgenössischer Dichterinnen beschreibt die KOSMOS SUITE die Reise durch ein menschliches Leben in fünf Sätzen: SPARK (Neubeginn), BLAST (Explosion), LIFE (Empathie), VOID (Angst), HOME (Heimkehr). Es geht um Fragen nach dem Warum, um Tod und Leben, Dunkelheit und Licht, Zeit, Sein, Verbundenheit, Verwirrung, Vertrauen und um unseren Platz als Individuum im großen Ganzen –dem Kosmos.
Drums: Julian Losigkeit
Kontrabass: Jan Dittmann
Trompete: Gabriel Rosenbach
Piano: Lukas DeRungs
Gesang: Maxine Eggers
3D Sound: Daniel Deboy (DELTA Soundworks)
Visuals: Benjamin Jantzen
Do., 9. Oktober, 20:00 Uhr | Dauer: ca. 65 Minuten
Eintritt: 25 Euro
Eine Hommage an eine geniale Band mit vielen originalen Musik-, Bild- und Videoaufnahmen und natürlich mit den größten Hits der Bandgeschichte. Die Kreativität ihrer Texte, die gewaltige Power ihrer Konzerte, die unvergleichliche Stimme Freddy Mercurys – all das spiegelt sich in dieser furiosen Musikshow im Retro-Stil wider. Erleben Sie Queen aus ungeahnter Nähe!
Empfohlen ab 16 Jahren | Dauer: ca. 90 Minuten
Eintritt: 15 Euro




ROCKET MEN nehmen Sie mit auf eine musikalische Reise durch das Universum. Die fünf Bandmitglieder sind jeweils in den Jazz- und Pop-Szenen von Hamburg, Berlin und Leipzig zu Hause – und verschmelzen das Beste aus den zwei Musik-Welten in ihrer einzigartigen Fusion. Cineastische Synthesizer-Sounds treffen auf rockige DrumGrooves und die ungehemmt treibenden Bläser-Lines von Trompete und Saxophon.
„Drum and Space“ nennen die fünf ihr selbst kreiertes Genre. Freuen Sie sich auf Dub, Brass-Band-Rhythmen und Jazz-Improvisationen, dazu satte Techno-Beats. Diese Reise ins Weltall wird nicht ohne heftige Erschütterungen ablaufen.
Mit ihrem Programm „Lost In Space“ präsentiert die Band ihre eigene Videoshow im Planetarium Hamburg.
Mi., 17. September & Do., 18. September jeweils 20:00 Uhr
Dauer: ca. 90 Minuten | Eintritt: 25 Euro
Die Astrophysikerin und Musikerin Dr. Mariana Wagner nimmt Sie in einer Mischung aus Live-Konzert und Wissensvermittlung mit auf eine Reise zu den Geräuschen des Universums. Lernen Sie die Herkunft dieser Klänge kennen und erleben Sie, wie zum Beispiel aus den Schwingungen im Inneren der Sonne ein Musikstück wird. Ein einzigartiger audiovisueller Ausflug durchs All.
Fr., 17. Oktober & Sa., 29. November, jeweils 20:00 Uhr
Dauer: ca. 75 Minuten | Eintritt: 19 Euro
In dieser preisgekrönten immersiven Show für die ganze Familie lauschen Sie den Klängen von Walen und Delfinen – begleitet von Live-Musik, Tanz, fesselnder visueller Kunst und atemberaubenden Unterwasseraufnahmen. Die Veranstaltung schafft es, Distanz zum stressigen Alltag aufzubauen und zugleich dazu zu inspirieren, sich für den Schutz der Unterwasserwelt einzusetzen.
Fr., 7. Nov., 19:00 Uhr & 21:00 Uhr | Dauer: ca. 70 Minuten
Eintritt: 29 Euro, ermäßigt 24 Euro




Gnadenlos pumpende Beats, raue Bass-Riffs, virtuose Gitarrensounds und unverwechselbarer Rock-Gesang: Erleben Sie legendäre Songs wie „Whole Lotta Love“,„Kashmir“ oder „Stairway to Heaven“ über die herausragende Soundanlage des Planetarium Hamburg. Dazu erwarten Sie surrealistische 360-Grad-Bildwelten sowie eine einmalige Licht-und Lasershow.
Empfohlen ab 16 Jahren | Dauer: ca. 60 Minuten
Eintritt: 14 Euro
Tabalugas Wecker ist kaputt. Natürlich denkt der kleine Drache, die Zeit sei stehen geblieben. Also macht er sich auf die Suche nach dem Wesen der Zeit. Staunend bewegt sich der kleine grüne Held durch eine Welt voller Rätsel.
Erzählt von Gregor Rottschalk, animiert nach den Bildern von Helme Heine und mit der unverwechselbaren Musik von Peter Maffay.
Empfohlen ab 12 Jahren | Dauer ca. 65 Minuten
Eintritt: 14 Euro
Ein einmaliger Ausflug ins Universum und eine Hommage an eine der erfolgreichsten Rock-Bands aller Zeiten: Pink Floyd. Es erklingen alle zehn Tracks des Albums, das sich bis heute über 50 Millionen Mal verkauft hat – inhaltlich und optisch geht es um Zeit und Raum. Ein immersives, allumfassendes SurroundSound-Erlebnis, das Sie die Realität transzendieren lässt!
Dauer: ca. 45 Minuten | Eintritt: 14 Euro
Mit diesem Set aus immer wieder neu ausgewählter Musik weckt DJ Raphaël Marionneau mit jeder Veranstaltung vollkommen andere Emotionen: Chillout, Ambient, elektronische Sounds und Deep House, begleitet von Visuals, die live gesteuert werden, nehmen das Publikum mit auf eine kosmische Reise. Lassen Sie sich vom Rhythmus der Musik und der Ruhe des Kosmos davontragen!
Do., 2. Oktober & Fr., 28. November, jeweils 20:00 Uhr
Dauer: ca. 150 Minuten (inkl. Pause) | Eintritt: 20 Euro




SAMANTHA HARVEY: UMLAUFBAHNEN
Sechs Astronauten und Astronautinnen aus unterschiedlichen Nationen umkreisen in einer Raumstation die Erde. Sechzehnmal an einem Tag sehen sie die Sonne auf- und wieder untergehen. Was passiert, wenn man seine Heimat nur aus weiter Ferne durch ein kleines Fenster wahrnimmt? Wie verändern sich Denken und Fühlen?

„Umlaufbahnen“ ist der fünfte Roman von Samantha Harvey und wurde unter anderem mit dem Booker Prize 2024 ausgezeichnet. Die Lesung im Planetarium ist nicht nur Teil des Harbour Front Literaturfestivals, sondern markiert zugleich eine Premiere: Es ist die erste Lesung des gefeierten Romans durch Samantha Harvey in Deutschland.
Di., 16. September, 19:30 Uhr | Dauer: ca. 90 Minuten Eintritt: 24 Euro, ermäßigt 19 Euro
In einer Zeit vor der Schrift war unser Sternenhimmel ein Kino der Nacht. Mit ihrer ungeheuren Einbildungskraft haben die Menschen in den Sternen ihre ältesten Kunstwerke geschaffen und ihre Kulturen dargestellt. Dieser Atlas versammelt 17 Sternenhimmel von allen Kontinenten: unser Großer Wagen war für die Maya ein Papagei, für die Inka der Gott des Gewitters, für die Araber eine Totenbahre. Raoul Schrott verbindet diese Sternsagen zu einem einzigartigen Epos der Menschheitsgeschichte.
Raoul Schrott, geboren 1964, ist Literaturwissenschaftler, Komparatist und Schriftsteller. Für seine Arbeit erhielt er schon zahlreiche Auszeichnungen, unter anderem den Peter-Huchel- und den Joseph-Breitbach-Preis.
Di., 30. September, 19:30 Uhr | Dauer: ca. 90 Minuten
Eintritt: 24 Euro, ermäßigt 19 Euro

Hamster Eddie will hoch hinaus. Doch bis dahin ist es ein weiter Weg. Noch wohnt der eifrige Nagetier-Wissenschaftler gemeinsam mit anderen Nagern auf einem Schrottplatz. Leider nimmt seine tierische Nachbarschaft seine ehrgeizigen Ambitionen alles andere als ernst. Ganz im Gegenteil – sie machen sich sogar über ihn lustig, als er ihnen stolz seine neueste Erfindung präsentiert: einen Fahrstuhl, der sie alle in größte Höhe bringen soll. Zu Eddies Enttäuschung scheitert sein Experiment. Es will einfach noch nicht so richtig klappen ...
Eines Tages hört Eddie einen lauten Knall in dem ein beschädigter Roboter liegt. Eddie

repariert ihn und findet heraus, dass er von einem Raumschiff gefallen ist, das immer noch die Erde umkreist. Von nun an setzt er alles daran, seinen neuen Freund zurück ins All zu bringen.
Spielerisch erfährt die ganze Familie, wie Flugzeuge und Raketen funktionieren und lernt gleichzeitig einiges über Aerodynamik, physikalische Gesetze und Astronomie.
EDDIE WILL INS ALL – kommt ihr mit?
Partially available in








Empfohlen ab 6 Jahren | Dauer: ca. 45 Minuten | Eintritt: 12 Euro, ermäßigt 7,50 Euro und entdeckt in seinem Garten einen Krater,



























































von der glühend heißen Oberfläche des Merkurs bis zum eisigen Pluto. Doch reicht ihr Treibstoff auch für den Rückweg zur Erde? Eine eindrucksvolle Planetenreise für die ganze Familie.

Empfohlen ab 6 Jahren | Dauer: ca. 45 Minuten







bei lernt er die Besonderheiten anderer Sterne kennen und entdeckt, dass sie sich zu Sternhaufen und Galaxien zusammenfinden. Er begegnet weiteren Sternen und erfährt, dass es manchmal etwas Besonderes sein kann, wenn man





















































Fledermaus Juri wohnt ganz oben im Planetarium. Er mit er wieder starten kann, müssen mehrere Rätsel gelöst werden. Helft Juri dabei und entdeckt mit ihm
leme und muss mitten im Sternensaal notlanden. Dadie Geheimnisse des Weltalls. Eine pädagogische Reise. Empfohlen ab 5 Jahren | Dauer: ca. 45 Minuten


Eine unterhaltsame und lehrreiche Reise zum Mitmachen mit den schönsten Liedern von Rolf Zuckowski. Spielerisch und musikalisch lernen die Kinder den Sonnenlauf, die Elemente und den Weg unseres Heimatplaneten Erde durch Raum und Zeit kennen. Untermalt durch liebevolle Illustrationen, Licht

James, ein Pinguin vom Südpol, trifft in der eisigen Welt des Nordpols den Eisbären Vladimir. Die beiden starten mit ihrem selbst gebauten Raumschiff eine Reise zu Mars und Saturn. Dabei stellen sie fest, dass die Planeten auch Tage, Nächte und Jahreszeiten haben. Beim Blick aus dem Weltraum auf die Erde finden sie außerdem heraus,
warum die Nächte unterschiedlich lang sind. Empfohlen ab 8 Jahren | Dauer: ca. 40 Minuten









chens: Zwei Weltraumfeen-Schwestern leben auf einem fernen Planeten. Eines Tages muss eine der beiden auf die Erde, um Gutes zu tun. Als armes Mädchen verschenkt sie all ihren Besitz an Mittellose. Während sie frierend im

Halten Sie die Karte so vor sich, dass die Markierung der Himmelsrichtung, in die Sie schauen, auf ihr nach unten weist.
Unsere Sternkarte zeigt den Himmel über Hamburg am 15. Oktober um 22 Uhr mit teleuropäische Sommerzeit (MESZ). Den selben Anblick haben wir am 15. Sep tember um Mitternacht und am 15. November um 19 Uhr mitteleuropäische Zeit (MEZ). Das Himmelspanorama verschiebt sich also pro Monat um zwei Stunden. Am 26. Oktober endet die Sommerzeit und unsere Uhren werden wieder um eine Stunde zurückgestellt. Ohne Umstellung entspräche 19 Uhr MEZ im November also 20 Uhr MESZ.
Betrachten wir nur die Sterne im Herbst ohne die Wandersterne (Planeten) und den flinken Mond. Jedes Jahr ziehen diese fernen Sonnen ihre gleichen Bahnen im Wandel der Jahres zeiten an unserem Himmel. Im Herbst zeigen sie sich nach den kurzen Sommer nächten wieder länger. Sehr leicht finden wir noch in südwestlicher Richtung das Sommerdreieck mit Wega in der Leier, Deneb im Schwan und Atair im Adler. Dane ben steht im Süden das Herbstquadrat. Drei Sterne
Monatlich aktuell finden Sie alles zum Sternenhimmel und zu unserem Sternenpodcast auf unserer Website: planetarium-hamburg.de/sternenhimmel


vom Pegasus und einer vom Sternbild Andromeda bilden dieses auffällige Viereck am Himmel. Fast senkrecht über uns fällt das „W“ der Kassiopeia auf. Rechts neben ihr finden wir den Kepheus, der wie das Haus vom Nikolaus aussieht, aber nicht so auffällig helle Sterne wie die Kassiopeia hat. Beide bilden ein Königspaar aus Äthiopien. Ihre Tochter ist die Andromeda, die Sternenkette, die sich links oberhalb an den Pegasus anschließt. Von dem mittleren Stern der Andromeda ausgehend entdecken wir rechts den Andromedanebel. Es ist die einzige unserer Nachbargalaxien, die wir unter normalen Bedingungen mit bloßem Auge am Nordhimmel sehen können. Links unterhalb des Herbstquadrats finden wir das Tierkreissternbild der Fische. Zwei Sternenketten sind am linken Ende verbunden und lassen sich am Himmel erahnen. Danach folgt im Tierkreis der Widder. Zwei seiner Sterne sind deutlich zu erkennen. Der Sternenbogen des Perseus zieht von der Kassiopeia Richtung Osten zum Horizont und endet im Siebengestirn der Plejaden. Sie gehören mit dem v-förmigen Stierkopf schon zu den Vorboten des funkelnden Winterhimmels.
Am Nordhorizont versteckt sich der Große Wagen. Seine hinteren Deichselsterne zeigen zum Polarstern im Kleinen Wagen. Geeinigt hat man sich aber auf die Namen Großer und Kleiner Bär für sie. Wie die Kassiopeia gehen sie in Hamburg
15:00 16:15 17:30 Sept.
Eddie will ins All – Ein Hamster hebt ab
Im Nachtflug durch die Galaxis
Sternbilder und ihre Legenden
Sept. 2. Di.
Sterntaler – Vom Universum belohnt
Space Tour 3D
Kleiner Stern im großen All
Planeten – Expedition durchs Sonnensystem
Aurora – Im Reich des Polarlichts
Die drei ??? – Das Dorf der Teufel
Sept. 3. Mi.
Meine Heimat – Unser blauer Planet
Wir sind Sterne 3D
Im Nachtflug durch die Galaxis
Polaris und das Rätsel der Polarnacht
Voyager – Die unendliche Reise 3D
Sept. 4. Do.
10:00 11:30 12:45 15:00 16:15 17:30 19:00 20:30 11:00 12:30 15:00 16:15 17:15 11:00 12:30 15:00 16:15 17:30 19:00 10:00 11:30 12:45 15:00 16:15 17:30 19:00 20:15 21:15
Mit Juri durchs Sonnensystem
Voyager – Die unendliche Reise 3D
Der Himmel über Hamburg im Sommer
Mo. 11:00 12:30 14:00 15:15 16:30 18:00 19:15
Eddie will ins All – Ein Hamster hebt ab
Verborgenes Leben
Schwarze Löcher – Mysteriöse Giganten im All
Space Tour
Der Himmel über Hamburg im Sommer
Die Zukunft des Universums
Aurora – Im Reich des Polarlichts
Best of Deep Space Night
Sept. 5. Fr. Sept. 6. Sa. Sept. 7. So. Sept. 8. Mo.
Das Geheimnis der Papierrakete
Die Chemie des Lebens – Das Unsichtbare in uns 3D
Sternbilder und ihre Legenden
Die dunkle Seite des Lichts
The Dark Side Of The Moon Planetarium Experience
Cosmic Jazz 12:00 13:15 14:45 16:00 17:30 19:00 21:00 22:45
Im Nachtflug durch die Galaxis
Wir sind Sterne 3D
Planeten – Expedition durchs Sonnensystem
Aurora – Im Reich des Polarlichts
Space Tour 3D
Die drei ??? – Das Dorf der Teufel
Queen Heaven – The Original Stairway to Heaven – Laser Zeppelin
Der kleine Tag – Das Sternenmusical
Die Apollo-Missionen zum Mond – Capcom Go! 3D
Eddie will ins All – Ein Hamster hebt ab
Der Himmel über Hamburg im Sommer
Schwarze Löcher – Mysteriöse Giganten im All
Voyager – Die unendliche Reise 3D
Tabaluga und die Zeichen der Zeit
spielfrei
spielfrei 12:00 13:30 14:30 15:45 16:45 17:45 19:00
Aurora – Im Reich des Polarlichts
spielfrei
spielfrei
Meine Heimat – Unser blauer Planet
Der kleine Major Tom
Die Zukunft des Universums
Sterntaler – Vom Universum belohnt
Planeten – Expedition durchs Sonnensystem
Space Tour 3D
Schwarze Löcher – Mysteriöse Giganten im All
13. Sa. Sept. 14. So. Sept. 15. Mo.
10:00 11:30 12:45 15:00 16:15 17:30 19:00 20:15 21:30 11:00 12:15 13:30 14:45 16:15 19:00
Verborgenes Leben
Die Zukunft des Universums
Sterntaler – Vom Universum belohnt
Sternbilder und ihre Legenden
Eddie will ins All – Ein Hamster hebt ab Wir sind Sterne 3D
Planeten – Expedition durchs Sonnensystem
Lange Nacht der Astronomie
Sternbilder und ihre Legenden
Aurora – Im Reich des Polarlichts
Kleiner Stern im großen All
Space Tour 3D
Im Nachtflug durch die Galaxis
Der kleine Prinz
spielfrei
Sternenreisen: Der Blick zu anderen Planeten, Sternen und Galaxien.
Planet Erde: Ausflüge in die Umwelt und rund um unseren blauen Planeten.
Musik & Kultur auf unserer Sternenbühne.
Veranstaltungen für Kinder und Familien.
Bei den Veranstaltungen des Planetarium Hamburg handelt es sich um „Infound/oder Lehrprogramme“ nach §14 JuSchG oder um Angebote, die eine FSK-Freigabe ohne Altersbeschränkung erhalten haben.
Mit Juri durchs Sonnensystem
Im Nachtflug durch die Galaxis
Verborgenes Leben
Eddie will ins All – Ein Hamster hebt ab Space Tour 3D
Samantha Harvey: Umlaufbahnen –
Lesung im Rahmen des Harbour Front Literaturfestivals
Meine Heimat – Unser blauer Planet
Sterntaler – Vom Universum belohnt
Aurora – Im Reich des Polarlichts
Rocket Men – Lost in Space
10:00 11:30 12:45 15:00 16:15 19:30 10:00 11:30 12:45 15:00 16:15 17:30 19:00 11:00 17:00 10:00 11:30 12:45 15:00 16:15 17:45 19:00 20:15 10:00 11:30 12:45 15:00 16:00 17:00 20:00 10:00 11:30 12:45 20:00 12:00 13:15 14:15 15:30 16:45 17:45 19:00 21:00 22:30
Die Apollo-Missionen zum Mond – Capcom Go! 3D
Sterntaler – Vom Universum belohnt
Eddie will ins All – Ein Hamster hebt ab Sternbilder und ihre Legenden
Wir sind Sterne 3D
Die Zukunft des Universums
Die drei ??? – Das Dorf der Teufel
Stairway to Heaven – Laser Zeppelin
Das Geheimnis der Papierrakete
Die Chemie des Lebens – Das Unsichtbare in uns 3D
Sternbilder und ihre Legenden
Polaris und das Rätsel der Polarnacht
Voyager – Die unendliche Reise 3D
Im Nachtflug durch die Galaxis
Rocket Men – Lost in Space
Wir sind Sterne 3D
Kleiner Stern im großen All
Verborgenes Leben
Die Zukunft des Universums
Space Tour 3D
Schwarze Löcher – Mysteriöse Giganten im All Planeten – Expedition durchs Sonnensystem
Aurora – Im Reich des Polarlichts
Sept. 20. Sa. Sept. 21. So. Sept. 22. Mo. Sept. 23. Di. -
Mit Juri durchs Sonnensystem
Planeten – Expedition durchs Sonnensystem
Die dunkle Seite des Lichts
Space Tour 3D
Aurora – Im Reich des Polarlichts
Im Nachtflug durch die Galaxis
The Dark Side Of The Moon Planetarium Experience 11:00 12:15 13:30 14:45 16:15 17:30 19:00 Sept. 16.
Queen Heaven – The Original
Präsentation der Sonnengangsuhr durch
Dr. Zarth am Stadtpark-See
Der Himmel über Hamburg im Herbst
Eddie will ins All – Ein Hamster hebt ab
Wir sind Sterne 3D
Die Apollo-Missionen zum Mond – Capcom Go! 3D
Der Himmel über Hamburg im Herbst
Die Zukunft des Universums
Die drei ??? und das Grab der Maya spielfrei im Sternensaal
Mit Juri durchs Sonnensystem
Im Nachtflug durch die Galaxis
Planeten – Expedition durchs Sonnensystem
Das Geheimnis der Papierrakete
Space Tour
Heino Falcke: Zwischen Urknall und Apokalypse 11:00 12:15 13:45 15:00 16:15 19:00
Die Chemie des Lebens – Das Unsichtbare in uns 3D
Eddie will ins All – Ein Hamster hebt ab
Verborgenes Leben
Der Himmel über Hamburg im Herbst
Voyager – Die unendliche Reise 3D
Jewish Chamber Orchestra: Jüdische
Sternstunden – Eine interstellare Reise zu Hamburgs jüdischen Komponistinnen Astronomischer Anfängerworkshop der GvA im Seminarraum
Der kleine Tag – Das Sternenmusical
Space Tour 3D
Schwarze Löcher – Mysteriöse Giganten im All
Planeten – Expedition durchs Sonnensystem
Aurora – Im Reich des Polarlichts
Sternbilder und ihre Legenden
Der Himmel über Hamburg im Herbst
Queen Heaven – The Original
10:00 11:30 12:45 15:00 16:15 19:30 12:00 13:30 14:45 15:45 16:45 18:00 19:00 21:00 22:30 10:00 11:30 12:45 15:00 16:15 17:30 19:00 20:30 10:00 11:30 15:00 16:15 17:30 19:30 19:30 10:00 11:30 12:45 15:00 16:15 19:30
Space Tour 3D
Eddie will ins All – Ein Hamster hebt ab
Kleiner Stern im großen All
Voyager – Die unendliche Reise 3D
Der Himmel über Hamburg im Herbst
Wir sind Sterne 3D
Die drei ??? – Das Dorf der Teufel
Cosmic Jazz
The Dark Side Of The Moon Planetarium Experience
Sterntaler – Vom Universum belohnt
Aurora – Im Reich des Polarlichts
Planeten – Expedition durchs Sonnensystem
Sternbilder und ihre Legenden
Space Tour
Kanada – Durch Weite und Wildnis
spielfrei
Der Himmel über Hamburg im Herbst
Der kleine Major Tom Wir sind Sterne 3D
Schwarze Löcher – Mysteriöse Giganten im All
Die Zukunft des Universums
Raoul Schrott: Atlas der Sternenhimmelund Schöpfungsmythen der Menschheit – Lesung im Rahmen des Harbour Front Literaturfestivals
Sternenreisen: Der Blick zu anderen Planeten, Sternen und Galaxien.
Planet Erde: Ausflüge in die Umwelt und rund um unseren blauen Planeten.
Musik & Kultur auf unserer Sternenbühne.
Veranstaltungen für Kinder und Familien.
Bei den Veranstaltungen des Planetarium Hamburg handelt es sich um „Infound/oder Lehrprogramme“ nach §14 JuSchG oder um Angebote, die eine FSK-Freigabe ohne Altersbeschränkung erhalten haben.
10:00 11:30 12:45 15:00 16:15 17:30
Mit Juri durchs Sonnensystem
Die Chemie des Lebens – Das Unsichtbare in uns 3D
Kleiner Stern im großen All
Planeten – Expedition durchs Sonnensystem
Im Nachtflug durch die Galaxis
Der Himmel über Hamburg im Herbst
Space Tour 3D
Die dunkle Seite des Lichts
Sternbilder und ihre Legenden
Verborgenes Leben
Aurora – Im Reich des Polarlichts
Die Zukunft des Universums
Voyage Cosmique – Raphaël Marionneau
Meine Heimat – Unser blauer Planet
Aurora – Im Reich des Polarlichts
Space Tour
Sterntaler – Vom Universum belohnt
Der Himmel über Hamburg im Herbst
Schwarze Löcher – Mysteriöse Giganten im All
The Dark Side Of The Moon Planetarium Experience
Queen Heaven – The Original
Wir sind Sterne 3D
Eddie will ins All – Ein Hamster hebt ab
Space Tour 3D
Planeten – Expedition durchs Sonnensystem
Aurora – Im Reich des Polarlichts
Die drei ??? und das Grab der Maya
Sterntaler – Vom Universum belohnt
Space Tour Okt. 2. Do. Okt. 3. Fr. Okt. 4. Sa. Okt. 5. So. Okt. 6. Mo. Okt. 7. Di. Okt. 8. Mi.
10:00 11:30 12:45 15:00 16:15 17:30 10:00 11:30 12:30 15:00 16:15 17:30 19:00
12:00 13:15 14:30 16:00 17:15 19:00 21:45 11:00 12:15 13:45 15:15 16:15 17:30 19:00 20:15 10:00 11:30 12:45 15:00 16:15 17:45 20:00 11:00 12:15 13:30 14:45 16:00 17:15 18:30 spielfrei
Best of Deep Space Night
Im Nachtflug durch die Galaxis
Polaris und das Rätsel der Polarnacht
Der Himmel über Hamburg im Herbst
Die dunkle Seite des Lichts
Die Chemie des Lebens – Das Unsichtbare in uns 3D
Mit Juri durchs Sonnensystem
Eddie will ins All – Ein Hamster hebt ab
Space Tour 3D
Der Himmel über Hamburg im Herbst
Im Nachtflug durch die Galaxis
Aurora – Im Reich des Polarlichts
Die drei ??? – Das Dorf der Teufel
Der Himmel über Hamburg im Herbst
Schwarze Löcher – Mysteriöse Giganten im All
Die Chemie des Lebens – Das Unsichtbare in uns 3D
Planeten – Expedition durchs Sonnensystem
Sternbilder und ihre Legenden
Verborgenes Leben
Mit Juri durchs Sonnensystem
Polaris und das Rätsel der Polarnacht
Wir sind Sterne 3D
Lukas DeRungs – Kosmos Suite 360°
10:00 11:30 12:45 15:00 16:15 17:15 11:00 12:30 13:45 15:00 16:15 17:30 19:00 12:00 13:15 14:30 15:45 17:00 19:00 21:45 10:00 11:30 12:45 15:00 16:15 19:30 10:00 11:30 12:45 15:00 16:15 17:30 19:00 10:00 11:30 12:30 20:00 spielfrei
Sterntaler – Vom Universum belohnt
Im Nachtflug durch die Galaxis
Aurora – Im Reich des Polarlichts
Der Himmel über Hamburg im Herbst
Space Tour 3D
Premiere: Cosmic Opera
Der Himmel über Hamburg im Herbst
Sternbilder und ihre Legenden
Schwarze Löcher – Mysteriöse Giganten im All
Verborgenes Leben
Aurora – Im Reich des Polarlichts
Die drei ??? und das Grab der Maya
Best of Deep Space Night
Der kleine Tag – Das Sternenmusical
Der Himmel über Hamburg im Herbst
Planeten – Expedition durchs Sonnensystem
Das Geheimnis der Papierrakete
Space Tour 3D
Der Himmel über Hamburg im Herbst
Cosmic Opera
13.
Okt. 14. Di. Okt. 15. Mi.
Die Apollo-Missionen zum Mond – Capcom Go! 3D
Planeten – Expedition durchs Sonnensystem
Im Nachtflug durch die Galaxis
Der kleine Major Tom
Space Tour 3D
Die Zukunft des Universums
Die drei ??? und das Grab der Maya
Mit Juri durchs Sonnensystem
Polaris und das Rätsel der Polarnacht
Der Himmel über Hamburg im Herbst
Die dunkle Seite des Lichts
Voyager – Die unendliche Reise 3D
Aurora – Im Reich des Polarlichts
Sternenreisen: Der Blick zu anderen Planeten, Sternen und Galaxien.
Planet Erde: Ausflüge in die Umwelt und rund um unseren blauen Planeten.
Musik & Kultur auf unserer Sternenbühne.
Veranstaltungen für Kinder und Familien.
Bei den Veranstaltungen des Planetarium Hamburg handelt es sich um „Infound/oder Lehrprogramme“ nach §14 JuSchG oder um Angebote, die eine FSK-Freigabe ohne Altersbeschränkung erhalten haben.
19.
Mit Juri durchs Sonnensystem
Space Tour 3D
Schwarze Löcher – Mysteriöse Giganten im All
Wir sind Sterne 3D
Im Nachtflug durch die Galaxis
Planeten – Expedition durchs Sonnensystem
Voss‘ Kosmos: Wasser – Eine kosmische
Geschichte
Sterntaler – Vom Universum belohnt
Das Geheimnis der Papierrakete
Die Chemie des Lebens – Das Unsichtbare in uns 3D
Planeten – Expedition durchs Sonnensystem
Eddie will ins All – Ein Hamster hebt ab
Space Tour
Sound Of Space – Konzert von Dr. Mariana Wagner
Der Himmel über Hamburg im Herbst
Verborgenes Leben
Eddie will ins All – Ein Hamster hebt ab
Kleiner Stern im großen All
Die Zukunft des Universums
Voyager – Die unendliche Reise 3D
Die drei ??? – Das Dorf der Teufel
Cosmic Opera
Cosmic Jazz
Meine Heimat – Unser blauer Planet
Planeten – Expedition durchs Sonnensystem
Sterntaler – Vom Universum belohnt
Der Himmel über Hamburg im Herbst
Schwarze Löcher – Mysteriöse Giganten im All
Planeten – Expedition durchs Sonnensystem
Queen Heaven – The Original
Okt. 20. Mo. Okt. 21. Di. Okt. 22. Mi. Okt. 23. Do.
10:00 11:30 12:45 15:00 16:15 17:30 19:30 11:00 12:30 15:00 16:15 17:30 19:00 20:15 21:30 19:30 11:00 12:30 15:00 16:00 17:00 11:00 12:15 13:30 14:45 16:00 17:15 18:45 12:00 13:15 14:30 15:45 16:45 18:00 19:00 21:00 22:30 10:00 11:30 12:45 15:00 16:15 17:30 20:00 11:00 12:30 13:45 14:45 16:00 17:00
Eddie will ins All – Ein Hamster hebt ab
Sterntaler – Vom Universum belohnt
Wir sind Sterne 3D
Planeten – Expedition durchs Sonnensystem
Voyager – Die unendliche Reise 3D
Die dunkle Seite des Lichts
11:00 12:30 15:00 16:15 17:30 19:00
Eddie will ins All – Ein Hamster hebt ab
Im Nachtflug durch die Galaxis
Der Himmel über Hamburg im Herbst
Space Tour 3D
Aurora – Im Reich des Polarlichts
Die drei ??? – Das Dorf der Teufel
Planeten – Expedition durchs Sonnensystem
Die Apollo-Missionen zum Mond – Capcom Go! 3D
Das Geheimnis der Papierrakete
Polaris und das Rätsel der Polarnacht
Der Himmel über Hamburg im Herbst
Der Himmel über Hamburg im Herbst
Space Tour 3D
Polaris und das Rätsel der Polarnacht
Im Nachtflug durch die Galaxis
Aurora – Im Reich des Polarlichts
Planeten – Expedition durchs Sonnensystem
Die Zukunft des Universums
The Dark Side Of The Moon Planetarium Experience
Astronomischer Anfängerworkshop der GvA im Seminarraum
Der kleine Tag – Das Sternenmusical
Im Nachtflug durch die Galaxis
Die dunkle Seite des Lichts
Voyager – Die unendliche Reise 3D
Frankenstein – Theater ex libris 11:00 12:30 15:00 16:15 17:30 19:00
Im Nachtflug durch die Galaxis
Polaris und das Rätsel der Polarnacht
Voyager – Die unendliche Reise 3D
Aurora – Im Reich des Polarlichts
Space Tour
Die drei ??? und das Grab der Maya
Schwarze Löcher – Mysteriöse Giganten im All
Verborgenes Leben
Eddie will ins All – Ein Hamster hebt ab
Der kleine Major Tom
Sternbilder und ihre Legenden
Die Zukunft des Universums
Die drei ??? – Das Dorf der Teufel
The Dark Side Of The Moon Planetarium Experience
Queen Heaven – The Original
11:00 12:30 15:00 16:15 17:30 19:30 11:00 12:30 13:45 15:00 16:00 17:15 11:00 12:15 13:30 15:00 16:15 19:00 12:00 13:15 14:30 15:30 16:30 17:45 19:00 21:00 22:15 11:00 12:30 15:00 16:15 17:30 20:15
Der Himmel über Hamburg im Herbst
Space Tour 3D
Planeten – Expedition durchs Sonnensystem
Schwarze Löcher – Mysteriöse Giganten im All
Die Chemie des Lebens – Das Unsichtbare in uns 3D
Kontor Sunset Chill
Der Himmel über Hamburg im Herbst
Kleiner Stern im großen All
Aurora – Im Reich des Polarlichts
Planeten – Expedition durchs Sonnensystem
Space Tour 3D
Kanada – Durch Weite und Wildnis
Sterntaler – Vom Universum belohnt
Aurora – Im Reich des Polarlichts
Verborgenes Leben
Sternbilder und ihre Legenden
Der Himmel über Hamburg im Herbst
Vortrag: Pionierinnen in der Physik –Prof. Dr. Dr. h.c. Beate Heinemann
Eddie will ins All – Ein Hamster hebt ab
Kleiner Stern im großen All
Die Apollo-Missionen zum Mond – Capcom Go! 3D
Das Geheimnis der Papierrakete
Wir sind Sterne 3D
Der Himmel über Hamburg im Herbst
11:00 12:30 15:00 16:15 17:30 18:45 20:00 21:15
Eddie will ins All – Ein Hamster hebt ab
Cosmic Opera Okt. 31. Fr.
Im Nachtflug durch die Galaxis
Wir sind Sterne 3D
Aurora – Im Reich des Polarlichts
Die Zukunft des Universums
Der Himmel über Hamburg im Herbst
Schwarze Löcher – Mysteriöse Giganten im All
Nov. 2. So.
12:00 13:15 14:15 15:30 16:45 18:00 19:00 21:45
Sterntaler – Vom Universum belohnt
Das Geheimnis der Papierrakete
Sternbilder und ihre Legenden
Der Himmel über Hamburg im Herbst
Planeten – Expedition durchs Sonnensystem
Wir sind Sterne 3D
Die drei ??? und das Grab der Maya
Queen Heaven – The Original
Nov. 3. Mo.
Planeten – Expedition durchs Sonnensystem
Space Tour 3D
Die dunkle Seite des Lichts
Im Nachtflug durch die Galaxis
Aurora – Im Reich des Polarlichts
Zu Fuß durch Deutschland
Mit Juri durchs Sonnensystem
Nov. 4. Di.
12:00 13:15 14:30 15:45 17:15 19:00 21:45 10:00 11:30 12:45 15:00 19:00 21:00 10:00 11:30 12:30 15:00 16:15 17:30 19:00 11:00 12:15 13:45 15:00 16:15 19:00 10:00 11:30 12:45 15:00 16:15 17:30
Eddie will ins All – Ein Hamster hebt ab
Die Chemie des Lebens – Das Unsichtbare in uns 3D
Die dunkle Seite des Lichts
Der Himmel über Hamburg im Herbst
Planeten – Expedition durchs Sonnensystem
Wir sind Sterne 3D 10:00 11:30 12:30 15:00 16:15 17:30 19:30
Mit Juri durchs Sonnensystem
Sterntaler – Vom Universum belohnt
Verborgenes Leben
Das Geheimnis der Papierrakete
Im Nachtflug durch die Galaxis
Sternbilder und ihre Legenden
Voss‘ Kosmos: Wie unterhält man sich mit Außerirdischen?
Polaris und das Rätsel der Polarnacht
Space Tour 3D
Schwarze Löcher – Mysteriöse Giganten im All
Der Himmel über Hamburg im Herbst
Aurora – Im Reich des Polarlichts
Die drei ??? – Das Dorf der Teufel spielfrei
Nov. 5. Mi. Nov. 6. Do. Nov. 7. Fr. Nov. 8. Sa.
Meine Heimat – Unser blauer Planet
Der Himmel über Hamburg im Herbst
Planeten – Expedition durchs Sonnensystem
Aurora – Im Reich des Polarlichts
Sounds of the Ocean
Sounds of the Ocean
Mit Juri durchs Sonnensystem
Sternbilder und ihre Legenden
Planeten – Expedition durchs Sonnensystem
Aurora – Im Reich des Polarlichts
Space Tour 3D
Die drei ??? und das Grab der Maya
Cosmic Opera
Der kleine Tag – Das Sternenmusical
Sterntaler – Vom Universum belohnt
Im Nachtflug durch die Galaxis
Der Himmel über Hamburg im Herbst
Voyager – Die unendliche Reise 3D
Schwarze Löcher – Mysteriöse Giganten im All
Der kleine Prinz 10:00 11:30 12:45 15:00 16:15 17:30 18:45 20:15
12:00 13:15 14:30 15:45 20:00 10:00 11:30 12:45 15:00 16:15 17:30 10:00 11:30 12:45 15:00 16:15 17:45 19:00 10:00 11:30 12:45 15:00 16:15 17:30 19:00 20:15 11:00 12:30 13:45 15:00 16:15 17:15 19:00
Sterntaler – Vom Universum belohnt
Der Himmel über Hamburg im Herbst
Aurora – Im Reich des Polarlichts
Der kleine Major Tom
Planeten – Expedition durchs Sonnensystem
Die Zukunft des Universums
Der Himmel über Hamburg im Herbst
Queen Heaven – The Original
Mit Juri durchs Sonnensystem
Polaris und das Rätsel der Polarnacht
Wir sind Sterne 3D
Eddie will ins All – Ein Hamster hebt ab Planeten – Expedition durchs Sonnensystem
Verborgenes Leben
The Dark Side Of The Moon Planetarium Experience Best of Deep Space Night
Planeten – Expedition durchs Sonnensystem
Die Zukunft des Universums
Space Tour
Der Himmel über Hamburg im Herbst
Aurora – Im Reich des Polarlichts
Verborgenes Leben
Die drei ??? und das Grab der Maya spielfrei
Der Himmel über Hamburg im Herbst
Sternbilder und ihre Legenden
Eddie will ins All – Ein Hamster hebt ab Space Tour 3D
Klaviere unterm Sternenhimmel
Mit Juri durchs Sonnensystem
Die dunkle Seite des Lichts
Kleiner Stern im großen All
Im Nachtflug durch die Galaxis
Sternbilder und ihre Legenden
Die Apollo-Missionen zum Mond – Capcom Go! 3D
Sternenreisen: Der Blick zu anderen Planeten, Sternen und Galaxien.
Planet Erde: Ausflüge in die Umwelt und rund um unseren blauen Planeten.
Musik & Kultur auf unserer Sternenbühne.
Veranstaltungen für Kinder und Familien.
Bei den Veranstaltungen des Planetarium Hamburg handelt es sich um „Infound/oder Lehrprogramme“ nach §14 JuSchG oder um Angebote, die eine FSK-Freigabe ohne Altersbeschränkung erhalten haben.
Klaviere unterm Sternenhimmel
Aurora – Im Reich des Polarlichts
Im Nachtflug durch die Galaxis
Schwarze Löcher – Mysteriöse Giganten im All
Tabaluga und die Zeichen der Zeit
Cosmic Jazz
11:00 14:00 15:30 16:45 18:00 19:30 11:00 12:15 13:30 14:45 16:00 17:15 19:00 12:00 13:15 14:30 15:45 16:45 18:00 19:00 21:15 22:30 10:00 11:30 12:45 15:00 16:15 17:15 20:00 10:00 11:30 12:45 15:00 16:30 20:00 10:00 11:30 12:45 15:00 16:15 17:30 19:00 20:15 21:30 19:30
Mit Juri durchs Sonnensystem
spielfrei
Sterntaler – Vom Universum belohnt
Die Chemie des Lebens – Das Unsichtbare in uns 3D
Das Geheimnis der Papierrakete
Space Tour 3D
Aurora – Im Reich des Polarlichts
Electric Lights – Women in Electronic Music
Der kleine Tag – Das Sternenmusical
Voyager – Die unendliche Reise 3D
Sternbilder und ihre Legenden
Die Zukunft des Universums
Wir sind Sterne 3D
Der Himmel über Hamburg im Herbst
Electric Lights – Women in Electronic Music
Nov. 20. Do. Nov. 21. Fr. Nov. 22. Sa. Nov. 23. So.
Kleiner Stern im großen All Im Nachtflug durch die Galaxis
Der Himmel über Hamburg im Herbst
Schwarze Löcher – Mysteriöse Giganten im All Space Tour 3D
Planeten – Expedition durchs Sonnensystem
Die Zukunft des Universums
Der Himmel über Hamburg im Herbst
Eddie will ins All – Ein Hamster hebt ab
Verborgenes Leben
Space Tour
Der Himmel über Hamburg im Herbst
Planeten – Expedition durchs Sonnensystem
Queen Heaven – The Original
The Dark Side Of The Moon Planetarium Experience Astronomischer Anfängerworkshop der GvA im Seminarraum 10:00 11:30 12:45 15:00 16:30 17:45 19:15 21:15
Cosmic Jazz
Sternbilder und ihre Legenden
Wir sind Sterne 3D
Schwarze Löcher – Mysteriöse Giganten im All
Eddie will ins All – Ein Hamster hebt ab Im Nachtflug durch die Galaxis
Voyager – Die unendliche Reise 3D
Die drei ??? – Das Dorf der Teufel
The Dark Side Of The Moon Planetarium Experience Stairway to Heaven – Laser Zeppelin
Meine Heimat – Unser blauer Planet
Der Himmel über Hamburg im Herbst
Polaris und das Rätsel der Polarnacht
Kleiner Stern im großen All
Im Nachtflug durch die Galaxis
Planeten – Expedition durchs Sonnensystem
Cosmic Opera
10:00 11:30 12:45 15:00 16:15 19:00 10:00 11:30 12:45 15:00 16:00 17:15 10:00 11:30 12:45 15:00 16:15 17:30 19:00
spielfrei
Mit Juri durchs Sonnensystem
Space Tour 3D
Sterntaler – Vom Universum belohnt
Voyager – Die unendliche Reise 3D
Planeten – Expedition durchs Sonnensystem
Aurora – Im Reich des Polarlichts
Die drei ??? – Das Dorf der Teufel
Die dunkle Seite des Lichts
Wir sind Sterne 3D
Die Zukunft des Universums
Polaris und das Rätsel der Polarnacht
Eddie will ins All – Ein Hamster hebt ab
Der Himmel über Hamburg im Herbst
Nov. 29. Sa.
Meine Heimat – Unser blauer Planet Im Nachtflug durch die Galaxis
Der Himmel über Hamburg im Herbst Space Tour 3D
Verborgenes Leben
Planeten – Expedition durchs Sonnensystem
Voyage Cosmique – Raphael Marionneau
Der kleine Major Tom
Planeten – Expedition durchs Sonnensystem
Space Tour
Aurora – Im Reich des Polarlichts
Schwarze Löcher – Mysteriöse Giganten im All
Premiere: Die drei ???
Nov. 30. So.
Der Himmel über Hamburg im Herbst
Planeten – Expedition durchs Sonnensystem
Polaris und das Rätsel der Polarnacht
Wir sind Sterne 3D
Aurora – Im Reich des Polarlichts
Im Nachtflug durch die Galaxis
Sound Of Space – Konzert Dr. Mariana Wagner
Queen Heaven – The Original
Sterntaler – Vom Universum belohnt
Die Himmelskinder-Weihnacht
Sternbilder und ihre Legenden
Space Tour 3D
Die Himmelskinder-Weihnacht
Die Zukunft des Universums
Die drei ???
Sternenreisen: Der Blick zu anderen Planeten, Sternen und Galaxien.
Planet Erde: Ausflüge in die Umwelt und rund um unseren blauen Planeten.
Musik & Kultur auf unserer Sternenbühne.
Veranstaltungen für Kinder und Familien.
Bei den Veranstaltungen des Planetarium Hamburg handelt es sich um „Infound/oder Lehrprogramme“ nach §14 JuSchG oder um Angebote, die eine FSK-Freigabe ohne Altersbeschränkung erhalten haben.
Montag geschlossen
10:00 - 17:00 Uhr
Dienstag 9:00 - 19:00 Uhr 10:00 - 19:00 Uhr
Mittwoch 9:00 - 17:00 Uhr 10:00 - 17:00 Uhr
Donnerstag 9:00 - 21:00 Uhr 10:00 - 21:00 Uhr
Freitag 9:00 - 21:00 Uhr 10:00 - 21:00 Uhr
Samstag 12:00 - 22:30 Uhr 12:00 - 22:30 Uhr
Sonn- und Feiertage 10:00 - 19:00 Uhr 10:00 - 19:00 Uhr
Unsere Tickets erhalten Sie online, telefonisch oder vor Ort. www.planetarium-hamburg.de
Tickethotline: 040 428 86 52 - 10
Montags bis freitags: 8:00 - 20:00 Uhr
Samstags: 10:00 - 18:00 Uhr

Sofern nicht anders bei den einzelnen Veranstaltungen angegeben, gelten folgende Preise.
Ein Umtausch oder die Rückgabe der Tickets ist nicht möglich.
Eintritt 12,00 EUR
Ermäßigt sowie Kinder und Jugendliche bis einschließlich 17 Jahre 7,50 EUR
Schulklassen, Berufsschulklassen, KiTa- und Krippengruppen 5,50 EUR Zuschlag für Vorstellungen in 3D 1,50 EUR
Ermäßigungen
Ermäßigungsberechtigt sind Schwerbehinderte mit einem GdB von 50 %, Schülerinnen und Schüler, Auszubildende, Studierende, Teilnehmende am Bundesfreiwilligendienst (BFD), am Freiwilligen Sozialen Jahr, am Freiwilligen Ökologischen Jahr, freiwillig Wehrdienstleistende sowie Erwerbslose und Empfangende von Leistungen nach dem II. und XII. Sozialgesetzbuch (Bürgergeld, Grundsicherung/Sozialhilfe). Bitte zeigen Sie entsprechende Nachweise unaufgefordert beim Einlass vor. Für Inhabende der Hamburg-Card gibt es bei Veranstaltungen in den Sparten „Planet Erde” und „Sternenreisen” eine Ermäßigung von 2,00 Euro für Erwachsene und 1,50 Euro für Kinder.
Buchungen für Gruppen
Schulklassen, Berufsschulklassen, KiTa- und Krippengruppen ab 12 Personen bezahlen 5,50 Euro pro Person. Bei Vorstellungen in 3D zzgl. 1,50 Euro Leihgebühr je 3D-Brille. Zwei begleitende Lehrkräfte haben freien Eintritt. Buchung nur telefonisch unter 040 / 428 86 52-10.
Gruppenbuchungen für Privatpersonen oder Firmen (ab 12 Personen) können per E-Mail unter info@plantetarium-hamburg.de angefragt werden.
Das Foyer des Planetarium Hamburg ist ebenerdig und rollstuhlgerecht. Den Sternensaal und die Aussichtsplattform erreichen Sie mit dem Fahrstuhl. Personen mit eingeschränkter Mobilität können unseren dafür ausgewiesenen Parkplatz direkt hinter dem Planetarium nutzen. Bitte fahren Sie in diesem Fall zum Parkplatz Linnering, dann nach links zur Schranke. Klingeln Sie bitte, wir öffnen Ihnen.
Für Rollstuhlfahrende haben wir im Sternensaal spezielle Plätze. Die Begleitung eines schwerbehinderten Menschen mit der Markierung ‚B‘ im Ausweis zahlt ermäßigten Eintritt.
Hörgeschädigte können bei vielen unserer Veranstaltungen den gesprochenen Ton per Induktionsschleife direkt über ihr Hörgerät empfangen, soweit das Gerät dies unterstützt. Sie können auch unser Audiosystem nutzen (Kopfhörer erhältlich an der Kasse). Damit erhalten Sie bei vielen Produktionen zudem Übersetzungen in andere Sprachen. Das Audiosystem wurde mit der freundlichen Unterstützung unseres Fördervereins angeschafft.
Bei Personen, die an photosensibler Epilepsie leiden, kann es durch schnell wechselnde Licht- und Lasereffekte im Sternensaal zu epileptischen Anfällen oder Bewusstseinsstörungen kommen. Der in einigen unserer Veranstaltungen eingesetzte künstliche Nebel ist gesundheitlich unbedenklich.
Planetarium Hamburg Linnering 1 (Stadtpark) 22299 Hamburg
Anreise mit öffentlichen Verkehrsmitteln U3 bis Borgweg oder U1 bis Hudtwalckerstraße, Bus 20 bis Haltestelle Ohlsdorfer Straße.
Anreise mit dem PKW Richtung City Nord zum Stadtpark Winterhude. Parkmöglichkeit am Linnering oder in der OttoWels-Straße.

Öffentliches W-LAN „PLH-Public“ Passwort: BackToSpace





Planetarium Hamburg
Linnering 1 22299 Hamburg presse@planetarium-hamburg.de
V.i.S.d.P.: Dr. Björn Voss, Thorsten Pück
Auflage: 60.000 Stück
Erscheinungsdatum: 1. Juli 2025
Redaktionsschluss: 30. April 2025, Änderungen vorbehalten
Layout & Gestaltung:
Christoph O. Hofbauer | www.christophhofbauer.de
Fabian Eglitis | Planetarium Hamburg
Icons Kategorien: Jonas Laugs | www.jfml.eu
Inhalte: Dr. Björn Voss, Christoph O. Hofbauer, Fabian Eglitis, Rahlf Hansen, Silke Damerow, Dr. Mariana Wagner
Lektorat: Christina Nollau | www.cncommunications.de
Druck: BONIFATIUS GmbH Druck – Buch – Verlag
www.blauer-engel.de/uz195
· ressourcenschonend und umweltfreundlich hergestellt
· emissionsarm gedruckt
· hauptsächlich aus Altpapier
Bildrechte: Titel: @iamalexanderlosch ALEXANDER ANTONY LOSCH Seite 3: NASA ESA and STSc | Mira Luna Geiger Seite 4: Planetarium Hamburg, Fabian Eglitis Seite 6: iStock Seite 7: iStock Seite 8: Evans & Sutherland, Christoph O. Hofbauer | NSC Creative | LWL/Perdok | Evans & Sutherland Seite 9: LWL Planetarium Münster/Perdok | DOUBLE DOME SAS | 123rf.com, Rostislav Zatonskiy, NASA, JPL-Caltech, Evans & Sutherland, Christoph O. Hofbauer Seite 10: Fulldome Studio DN | Render Area | NASA | UMA Vision Seite 11: Jörg Müller | Mira Luna Geiger | ESO/S.Deiries | NASA Seite 12: Planetarium Brno Seite 13: Visualization by NASA‘s Goddard Space Flight Center based on data from the Earth Observation Group, NOAA National Geophysical Data Center. Visualizer: Marit Jetoft-Nilsen Seite 14: Kwon O Chul | Visualisierungscenter C Seite 15: Achill Moser & Aaron Moser | Achill Moser & Aaron Moser Seite 16: Planetarium Hamburg, ChatGPT4o, Lukas Christiansen Seite 17: Planetarium Hamburg Seite 18: Planetarium Hamburg, Fabian Eglitis | Planetarium Hamburg, Fabian Eglitis | Karl Rauch Verlag | Franckh-Kosmos Verlags-GmbH & Co. KG Seite 19: Franckh-Kosmos Verlags-GmbH & Co. KG | Franckh-Kosmos Verlags-GmbH & Co. KG | Katja Ruge Seite 20: Hanno Endres | Boris Breuer | Jewish Chamber Orchestra Hamburg Seite 21: Planetarium Hamburg, ChatGPT4o, Fabian Eglitis | Kontor Music Seite 22: Lukas DeRungs | Queen Productions Ltd Seite 23: David Lössl | Mira Luna Geiger | Embodied Sounds Seite 24: Clark Planetarium | The Content Dome | NSC Creative | Planetarium Hamburg Seite 25: dtv Verlagsgesellschaft | Carl Hanser Verlag Seite 26: Krutart Seite 27: Krutart Seite 28: Clark Planetarium | Softmachine| Boosey & Hawkes Deutschland GmbH für Musik für Dich Rolf Zuckowski OHG | Audiovisual Imagineering AVI Seite 29: Fabian Eglitis, Dall-E | Musik für Dich Rolf Zuckowski OHG | Planetarium de Saint-Etienne | Jan Siggel Seite 30/31: Katja Frauenkron, Planetarium Hamburg Seite 45: Openstreetmap.org/copyright